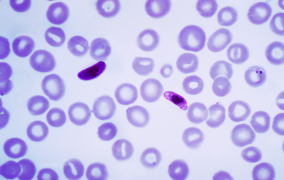

Oportunidades - Bolsas FAPESP
-
Pós-doutorado em psicologia e educação moral na Faculdade de Educação da USP
05 de novembro de 2025Candidato deve ter domínio da Teoria dos Modelos Organizadores do Pensamento; é desejável conhecimento no campo da neurociência -
Pós-doutorado em química, espectroscopia e nanotecnologia na USP
04 de novembro de 2025Oportunidade exige experiência nas áreas de microscopia hiperespectral, espectroscopia Raman, ressonância plasmônica de superfícies, catálise e nanocatálise -
Centro de Ciência para o Desenvolvimento abre vaga de pós-doutorado
04 de novembro de 2025É essencial que o candidato seja médico veterinário com experiência comprovada em coordenação de projetos de pesquisa com animais silvestres -
Doutorado, doutorado direto e mestrado em virologia na USP de Ribeirão Preto
03 de novembro de 2025Atividades dos bolsistas de doutorado incluem treinamento em técnicas celulares e moleculares e em isolamento de células primárias de sangue periférico -
Iniciação científica em ciências biológicas e bioinformática na USP
03 de novembro de 2025Candidatos devem atender a pelo menos um dos pré-requisitos: ingresso por olimpíadas de conhecimento, ações afirmativas, Provão Paulista ou ter cursado todo o ensino médio em escola pública -
Centro de Pesquisa em Resiliência em Crises Climáticas e Desastres abre vaga de pós-doutorado
31 de outubro de 2025Busca-se candidato com doutorado em ciências sociais, sociologia, antropologia, ambiente e sociedade ou áreas afins -
Iniciação científica em ensino de química na USP
31 de outubro de 2025Candidato deve estar regularmente matriculado em curso de graduação em química e não possuir previsão de conclusão nos próximos 12 meses -
Bolsa de jornalismo científico em fisiologia e biomedicina na USP
30 de outubro de 2025Bolsista vai desenvolver e publicar conteúdos digitais para redes sociais, incluindo vídeos, videorreportagens, textos e podcasts -
Pós-doutorado em genética e melhoramento animal em Centro de Ciência para o Desenvolvimento
30 de outubro de 2025Candidato deve ter experiência comprovada em metodologias de avaliação genética e genômica e ferramentas ômicas -
Treinamento técnico em ciência da computação em empresa com apoio PIPE
30 de outubro de 2025É desejável que o candidato tenha experiência comprovada em Python, programação orientada a objetos, desenvolvimento de APIs e processamento de dados -
Centro de Pesquisa em Resiliência em Crises Climáticas e Desastres abre vaga de pós-doutorado
29 de outubro de 2025Pesquisador integrará estudo sobre hidrogênio geológico e abatimento de carbono, baseado no aprendizado de máquina -
Centro de Pesquisa de Lignina Grafitizada abre vaga de pós-doutorado
29 de outubro de 2025Bolsista atuará no desenvolvimento de metodologias para grafitização de lignina por irradiação de micro-ondas -
Pós-doutorado em transporte caótico de partículas em plasmas na USP
29 de outubro de 2025Oportunidade requer bom histórico acadêmico de pós-graduação, com doutorado a ser concluído até o início do projeto ou concluído há menos de 12 meses -
Centro de Estudos de Carbono em Agricultura Tropical abre vaga de pós-doutorado
28 de outubro de 2025É desejável que o candidato tenha doutorado na área de ciência do solo e experiência em estudo com reaproveitamento de resíduos e geoquímica do solo -
Pós-doutorado em química inorgânica no Ipen
28 de outubro de 2025Bolsista vai trabalhar em projeto que desenvolve design de novos ligantes orgânicos para formar complexos com íons lantanídeos trivalentes -
Centro Multidisciplinar para o Desenvolvimento de Tecnologia Assistiva abre vaga de doutorado
24 de outubro de 2025Candidato deve ter graduação na área de educação física ou fisioterapia e mestrado na área de ciências do movimento -
Treinamento técnico em biologia celular na Faculdade de Ciências Farmacêuticas da USP
24 de outubro de 2025Bolsista vai integrar projetos em andamento na área de descoberta de fármacos e sinalização celular em malária -
Pós-doutorado em fisiologia comparada no Instituto de Biociências da USP
23 de outubro de 2025Candidato deve ter doutorado em ciências biológicas ou áreas afins e ser capaz de coordenar um projeto de pesquisa -
Pós-doutorado em tecnologia nuclear no Ipen
23 de outubro de 2025É necessário para a vaga ter capacidade de produção demonstrada pela publicação recente de artigos em periódicos internacionais -
Treinamento técnico em ciência de dados na USP Leste
22 de outubro de 2025Vaga requer domínio de software de análise de dados e uso de plataforma para aplicação de dados primários sobre as Organizações da Sociedade Civil (OSCs) -
Centro de Pesquisa para Inovação em Gases de Efeito Estufa abre vaga de pós-doutorado
22 de outubro de 2025Candidato deve ter doutorado em química, engenharia química ou áreas afins com experiência em caracterização de materiais e catálise -
Centro de Pesquisa em Genômica Aplicada às Mudanças Climáticas tem vaga de pós-doutorado
22 de outubro de 2025Entre as qualificações do candidato, é desejável que tenha doutorado com experiência em programação e análise de dados de bioinformática -
Centro de Pesquisa em Biologia de Bactérias e Bacteriófagos abre vaga de pós-doutorado
22 de outubro de 2025Candidato deve ter experiência em biologia molecular, bioquímica de proteínas e genética bacteriana; é desejável experiência em biologia estrutural -
Pós-doutorado em coprodução do conhecimento no Instituto de Biociências da USP
22 de outubro de 2025Vaga requer experiência básica em taxonomia botânica, habilidades de reflexividade e sensibilidade para múltiplos contextos culturais -
Pós-doutorado em conservação da biodiversidade e treinamento técnico em ciências ambientais na USP de Ribeirão Preto
21 de outubro de 2025Candidato ao pós-doc deve ter competências práticas em coleta de dados quali-quantitativos, com experiência em projetos transdisciplinares e em análise de dados espaciais; candidato ao TT-2 deve ter conhecimento básico de informática e de plataformas de mapeamento e estatística -
Pós-doutorado em tecnologia de alimentos na Unicamp
21 de outubro de 2025Candidato deve ter doutorado concluído há menos de sete anos e experiência prévia com produtos de origem animal e microbiologia de alimento -
Pós-doutorado em física dos materiais no Instituto de Física da USP
20 de outubro de 2025Entre as habilidades desejadas para a vaga estão experiência em preparação de amostras e caracterizações básicas e escrita em inglês -
Centro de Inovação em Produção de Energia abre vaga de pós-doutorado
20 de outubro de 2025É necessário ter doutorado em engenharia com conhecimentos de processamento de sinais, estatística e habilidade na programação de computadores -
Centro de Inovação em Tecnologia Offshore tem vaga de pós-doutorado e treinamento técnico
20 de outubro de 2025Para as duas vagas é preciso ter experiência em áreas relacionadas à computação, matemática aplicada, física, estatística, engenharia elétrica, eletrônica ou industrial -
Treinamento técnico em bioinformática na Faculdade de Medicina da USP
17 de outubro de 2025Candidato deve ter experiência em processamento de dados brutos e análise de exoma e sequenciamento de RNA tumoral -
Pós-doutorado em agronomia e ciência do solo na USP de Piracicaba
17 de outubro de 2025Vaga requer experiência comprovada em pedometria, sensoriamento remoto do solo, modelagem preditiva, carbono orgânico do solo e ciência de dados -
Centro de Pesquisa e Inovação de Materiais Inteligentes e Quânticos tem vaga de pós-doutorado
17 de outubro de 2025Candidato deve ter conhecimento sólido em síntese de nanopartículas por diferentes rotas químicas e experiência comprovada em técnicas clássicas de caracterização de laboratório -
Pós-doutorado em infectologia na Escola Paulista de Medicina da Unifesp
17 de outubro de 2025Para a vaga é importante dominar técnicas de citometria de fluxo e cromatografia líquida acoplada a espectrometria de massas em tandem -
Centro para Segurança Hídrica e Alimentar em Zonas Críticas abre vaga de pós-doutorado
16 de outubro de 2025Oportunidade requer experiência em radar meteorológico, desenvolvimento de softwares de nowcasting e programação computacional -
Pós-doutorados em sociologia na USP
16 de outubro de 2025Serão escolhidos dois candidatos com experiência em metodologias quantitativas ou qualitativas -
Pós-doutorado e treinamento técnico em governança colaborativa na USP Leste
16 de outubro de 2025Pós-doutorando desenvolverá uma metodologia que será aplicada à coleta de dados empíricos e possibilitará a formulação de políticas públicas mais eficazes -
Iniciação científica em análise de dados na UFABC
15 de outubro de 2025São duas vagas que exigem conhecimento em programação -
Treinamento técnico em biologia celular na Faculdade de Ciências Farmacêuticas da USP
15 de outubro de 2025Bolsista terá a oportunidade de atuar em um ambiente colaborativo e internacional, integrando abordagens de bioquímica, biologia molecular, química medicinal e biologia de sistemas -
Centro Plataforma Tecnológica em Sanidade Animal abre vaga de mestrado
14 de outubro de 2025Candidatos devem ter, preferencialmente, formação em administração, biologia, economia, veterinária ou áreas afins -
Pós-doutorado em oncologia no Instituto de Ensino e Pesquisa do Hospital de Amor
14 de outubro de 2025Candidato deve ter doutorado concluído até dezembro de 2025 e experiência mínima de dois anos em infravermelho por transformada de Fourier aplicada à oncologia -
Centro de Inovação em Produção de Energia abre vaga de pós-doutorado
13 de outubro de 2025Pesquisador selecionado atuará em projeto voltado à caracterização de fluidos sob altas pressões -
Pós-doutorado em engenharia elétrica e agrícola na Unicamp
13 de outubro de 2025Vagas requerem experiência na área de sensoriamento remoto e disponibilidade para residir na região de Campinas -
Treinamento técnico em georreferenciamento na UFSCar
13 de outubro de 2025Candidato deve ter experiência mínima de quatro anos e conhecimento no uso de drones e integração de dados -
Pós-doutorado em cultura celular e pré-eclâmpsia na Unesp de Botucatu
13 de outubro de 2025Oportunidade exige título de doutor na área de ciências biomédicas ou afins, com experiência em cultura celular 3D, western blotting e zimografia -
Pós-doutorado em fotobiologia na UFSCar
13 de outubro de 2025Candidato deve ter experiência comprovada em biologia molecular, expressão heteróloga e purificação de proteínas e ensaios enzimáticos, entre outros -
Treinamento técnico em organização de dados na UFSCar
10 de outubro de 2025Vaga requer domínio de organização de dados e ferramentas digitais. É desejável experiência com bancos de dados e softwares como PostgreSQL, Excel, QGIS ou similares -
Centro de Pesquisa para Inovação em Gases de Efeito Estufa abre vaga de pós-doutorado
10 de outubro de 2025Candidato deve ser doutor em engenharia mecânica ou em áreas correlatas -
Pós-doutorado em bioquímica e fisiologia na USP
10 de outubro de 2025Candidato deve ter doutorado em biologia, fisiologia, farmacologia, bioquímica ou química. Experiência com cultura celular e metabolismo mitocondrial será valorizada -
Pós-doutorado em ciências ambientais na Unesp de São Vicente
10 de outubro de 2025São habilidades desejáveis para a vaga: domínio de R, mineração e sistematização de dados e experiência em oficinas participativas -
Pós-doutorado em políticas públicas da reforma agrária na UFSCar
10 de outubro de 2025É necessário que o candidato tenha experiência de pesquisa com desenvolvimento e inovação tecnológica para agricultura familiar
Mais lidas do mês
-
Morrem as pesquisadoras Erotilde Pezatti e Carmen Lúcia Soares
01 de julho de 2026
-
Grandes mamíferos alteram a química do solo e aumentam a fertilidade da Mata Atlântica
01 de julho de 2026
-
Uso de suplemento antes de cirurgia melhora regeneração do fígado
06 de julho de 2026
-
Musculação reprograma células do fígado e ajuda a reverter danos da obesidade
02 de julho de 2026
-
Avanço de árvores no Cerrado causa a morte de plantas rasteiras por inanição
06 de julho de 2026
-
Árvores gigantes de florestas tropicais superam limites físicos para transportar água até o topo
02 de julho de 2026
-
Látex de jaca combinado com estatinas mostra potencial contra a periodontite
01 de julho de 2026
-
Estudo explica como o parasita da doença de Chagas ‘ativa’ sua forma capaz de infectar mamíferos
02 de julho de 2026
-
FAPESP, Unicamp e Funcamp assinam convênio de cooperação institucional
03 de julho de 2026
-
Oscilações quânticas anômalas revelam nova física em isolante topológico
02 de julho de 2026